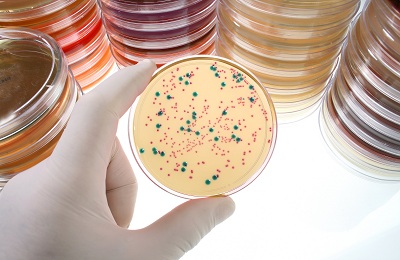

У Медичному центрі із незалежною лабораторією “Biotek” Ви можете пройти дослідження
Антибіотикограма – це вид бактеріологічного дослідження, метою якого є визначення чутливості чи стійкості мікроорганізмів до антибіотиків. Аналіз проводять для визначення правильного лікування.
Чому важлива антибіотикограма?

Винахід антибіотиків кардинально змінив історію медицини та дозволив людству перемагати захворювання, які раніше вважалися невиліковними. Але сьогодні їхня ефективність перебуває під загрозою. Дедалі більше інфекцій – наприклад, пневмонію, туберкульоз, зараження крові, гонорею, захворювання харчового походження – стає важче, інколи ж і неможливо лікувати через зниження ефективності антибіотиків.
Через неправильне та надмірне використання препаратів, а також слабку профілактику інфекцій та боротьбу з ними, стійкість до антибіотиків стрімко набирає темпи.
Якщо не вжити відповідних захисних заходів, безліч поширених інфекцій більше не будуть піддаватися лікуванню і знову призводитимуть до летальних наслідків.
Для боротьби зі стійкістю до антимікробних препаратів необхідно дотримуватись деяких правил:
- приймати антибіотики лише за призначенням кваліфікованого лікаря та завжди доводити лікування до кінця. Проведення пацієнтами лише частини курсу лікування сприяє розвитку стійкості до ліків.
- ніколи не приймати антибіотики, якщо в них немає потреби;
- завжди дотримуватись рекомендацій лікаря при використанні антибіотиків;
- не рекомендувати іншим особам антибіотики, які допомогли конкретно вам; кожен випадок захворювання повинен діагностувати кваліфікований лікар та призначати відповідне лікування;
- запобігати зараженню відповідно до «П’яти найважливіших принципів безпечного харчування» – регулярно мити руки, дотримуватися гігієни під час приготування їжі, уникати тілесного контакту з хворими, практикувати безпечний секс та вчасно робити щеплення.
Важливо розуміти, що антибіотики призначені для боротьби з бактеріальними інфекціями та не діють проти вірусних інфекцій, таких як грип чи ГРВІ.
Для того щоб підібрати необхідні препарати, потрібно до призначення лікування взяти у хворого матеріал для дослідження, виділити чисту культуру збудника та визначити його чутливість до антибіотиків – антибіотикограму.
Антибіотикограма – це вид бактеріологічного дослідження, метою якого є визначення чутливості чи стійкості мікроорганізмів до антибіотиків. Для швидкої та ефективної боротьби з інфекцією важлива точність та швидкість вибору антимікробних препаратів, а також визначення виду мікроорганізмів.
Для цього наша незалежна лабораторія “Biotek” використовує сучасне обладнання: французький автоматичний мікробіологічний аналізатор
Vitek 2 Compact.

Аналізатор дає можливість:
• Проводити ідентифікацію всіх клінічно значущих мікроорганізмів (ентеробактерії, стафілококи, стрептококи, псевдоманади, нейссерії, гемофіли, анаероби та ін.).
• Визначати чутливість (МІК) до 19-22 антибіотиків з їх інтерпретацією (резистентний R або чутливий мікроорганізм S до даного антибіотика).
• Система видає відповідь протягом 4-9 годин після початку аналізу приладом.
• Виявляти механізми резистентності виділеного штаму (наприклад, β-лактамази розширеного спектру, пеніцилінази).
• Можлива терапевтична інтерпретація результатів експертною системою з метою вибору коректної антибіотикотерапії.
Наявність бактерій у крові може викликати низку серйозних наслідків. Тому дуже важливою є швидкість дослідження крові на стерильність. Для цього ми використовуємо систему
Васт/ALERT 3D
Переваги використання системи:

- істотне скорочення часу визначення позитивних посівів крові, ліквору та інших рідин організму (переважна більшість мікроорганізмів виявляється протягом першої доби);
- спеціальні флакони з активованим вугіллям, що інактивує дію антибіотиків та токсичних компонентів дозволяють проводити аналіз зразків пацієнтів, які проходять курс антибіотикотерапії;
- число маніпуляцій із флаконами зведено до мінімуму (зразок вноситься шляхом проколювання гумової пробки), що значно скорочує можливість контамінації зразка;
- збільшення висівання збудника на 30% порівняно з ручними методами;
- наявність педіатричних флаконів дає змогу достовірно досліджувати зразки крові до 4 мл;
- немає необхідності використовувати додаткові флакони при підозрі на фунгемію – флакони для аеробів дозволяють ефективно виявляти гриби;
- швидке та високочутливе виявлення збудників забезпечує лікарів – клініцистів інформацією, необхідною для своєчасного визначення та проведення оптимальної та ефективної (у тому числі й економічно) терапії та своєчасної її корекції у найважчих хворих з такими захворюваннями як сепсис, важка пневмонія, бактеріальний ендокардит, перитоніт, менінгіт.


